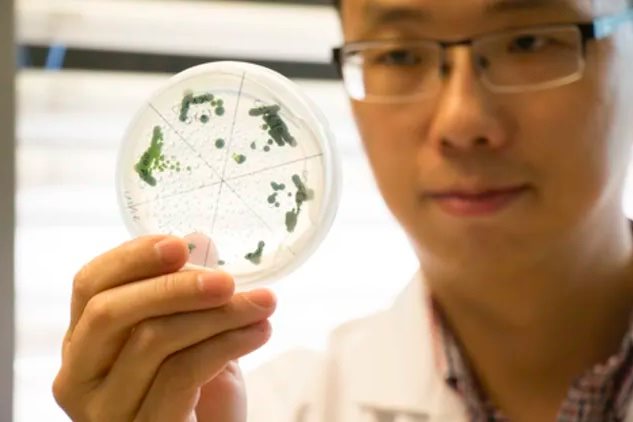

Microalgae to help capture carbon from power plants in new research venture
2 Mar 2023

US researchers have been awarded a $2 million grant from the Department of Energy to explore the potential of microalgae to absorb CO₂ emissions from industrial power plants.
Related Topics: Carbon News world Science Technology

Climate Leaders Coalition on PM meetings: 'it wasn’t us'
Mon 25 May 2026
By Pattrick Smellie | The 81-member Climate Leaders Coalition is distancing itself from the actions of members who lobbied the Prime Minister’s Office to intervene and stop a landmark climate change court case.

Corporate coddling is killing our climate
Mon 25 May 2026
By Matt Halliday | COMMENT: The New Zealand Government’s recent move, undercutting citizens’ rights and the rule of law to cancel the country’s most important climate case, Smith v Fonterra, is a massive victory for corporate lobbying.

Mike Smith’s asymmetric victory
Mon 25 May 2026
By Pattrick Smellie | COMMENT: The New Zealand Government’s recent move, undercutting citizens’ rights and the rule of law to cancel the country’s most important climate case is a massive win for Mike Smith, the climate change activist who brought it.

Govt ramps up war on wilding pines with $79m boost
Mon 25 May 2026
By Shannon Morris-Williams | The Government is ramping up efforts to contain the spread of wilding pines with a $79 million funding boost aimed at protecting farmland, biodiversity hotspots, tourism landscapes and water catchments across New Zealand.

Rotorua extends diesel bus contract after NZTA declines extra funding
Mon 25 May 2026
By Mathew Nash, Local Democracy Reporter | Rotorua is stuck with its diesel-powered public buses after a funding snag played a part in setting back plans for zero-emission buses by years.

Marae solar project boosts sustainability and mana motuhake
Mon 25 May 2026
By Moana Ellis, Local Democracy Reporter | Five marae from Whanganui to Taumarunui are running on solar power and many more could join a major green energy initiative aimed at cutting electricity costs and strengthening community resilience.

Govt had ‘little choice’ in signing key UN climate resolution – expert
Fri 22 May 2026
By Shannon Morris-Williams | Climate policy expert Bronwyn Hayward said it was “shameful’ New Zealand didn’t throw more active support behind a pivotal climate resolution ratified by the United Nations this week.

NZ at risk of falling behind on EV transition
Fri 22 May 2026
By Shannon Morris-Williams | An EV lobby group is warning that New Zealand is at a crossroads on transport electrification, with inconsistent policy settings and lagging charging infrastructure slowing uptake, while global adoption accelerates and fuel price shocks renew interest in electric vehicles.

New DOC chief appointed as public sector cuts loom
Fri 22 May 2026
By Shannon Morris-Williams | Peter Chrisp has been appointed the new Director-General of Conservation, just as the Department of Conservation again finds itself in the firing line of the Government’s public sector cost-cutting programme.

Media round-up
Fri 22 May 2026
In our round-up of climate coverage in local media: Shane Jone is urging mining bosses to apply for fast-track before the election, climate risk is changing where investors put their money, and Hiringa gets more hydrogen-fuelled trucks on the road.
